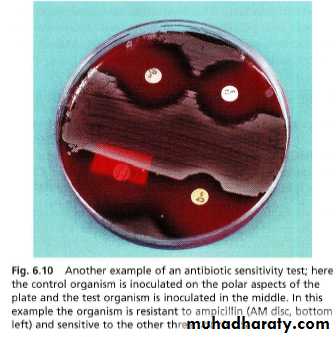

Diagnostic microbiology andlaboratory methods
Dr.Ghada younis21-10-2013 ,………
Non-cultural methods. These are many and varied, and include:
• microscopic methods (light microscopy, electron microscopy)• detection of microbes by probing for their genes using molecular tools
• Cultural methods. Classic methods of diagnosis, in which:
solid or liquid media are used for bacterial and fungal growth
• cultured cells derived from animals and humans are
used for viral growth
• Immlunological methods. These are used to:
• identify organisms
• detect antibodies in a patient's body fluids (e.g. serum,
saliva), especially when the organism cannot be cultured
in laboratory media